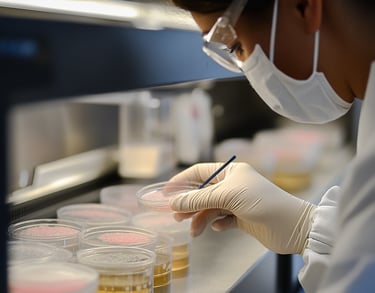

📞Call or Text (949)298-3860

Top-Rated Mold Testing, Inspection, and Remediation Services in Tustin
Looking for Mold Inspection and Testing Near You in Tustin?
Mold Testing Pro offers reliable mold inspection, testing, and remediation services in Tustin. We help homeowners, renters, and businesses quickly identify and remove mold with certified reports and effective cleanup solutions for a safer, healthier space.


Tustin, CA blends historic charm with modern living, featuring everything from vintage homes to new developments. However, aging plumbing in older neighborhoods and seasonal humidity throughout the year can create ideal conditions for mold to grow undetected.
That’s why we offer expert mold inspection and mold testing services in Tustin to help identify issues early. When needed, our certified mold remediation team delivers thorough, efficient solutions to restore healthy indoor air quality and protect your investment.






Our services
Mold Inspection and Testing
Post Mold Remediation Verification
Mold Remediation
Air Sampling
Surface Sampling
Thermal Camera Inspection
Mold Remediation and Removal Services in Tustin
Tustin’s mix of historic homes and modern buildings makes it especially vulnerable to mold caused by leaks, poor ventilation, or past water damage. Our certified experts provide fast, effective mold remediation, mold removal, and thorough cleanup to protect your property and health.
We locate the source, eliminate mold safely, and restore clean indoor air—ensuring lasting results. Whether it’s your home or business, we’re available 24/7 to respond quickly and professionally. Call today for a free mold inspection in Tustin and let our local team help you breathe easier.

Your Trusted Mold Inspection Experts
At Dr. Mold Pro, we specialize in expert mold testing and inspection services throughout Orange County, ensuring a healthier environment for homes and businesses with fast, reliable solutions.
480+
100%
Client Satisfaction Guarantee
Mold Inspections Completed
Our Mold Inspection and Testing Process in 5 Simple Steps
Schedule an Appointment
Mold Inspection & Testing Performed
Mold Tests Sent to Independent Lab
Lab Results and Reports Sent via Email
Full Customer Support
Book Your Appointment
Dr Mold Pro combines certified expertise with the latest AI tools and top-of-the-line technology to deliver accurate mold inspection and testing. Our licensed inspectors use smart moisture meters, thermal imaging, and lab-certified sampling to detect hidden mold quickly and reliably
Customer reviews
Discover what our clients think about our service in Tustin
They found mold under our stairs that had spread from a pipe. They caught it before it got worse. So thankful for the fast response.
Benjamin G. - Tustin
This was my first time hiring a mold inspector and I’m glad I chose them. Clear process and no confusion. I’d recommend them to anyone.
Phoebe W. - Tustin



Zip Codes We Service in Tustin
92606, 92705, 92780, 92781






